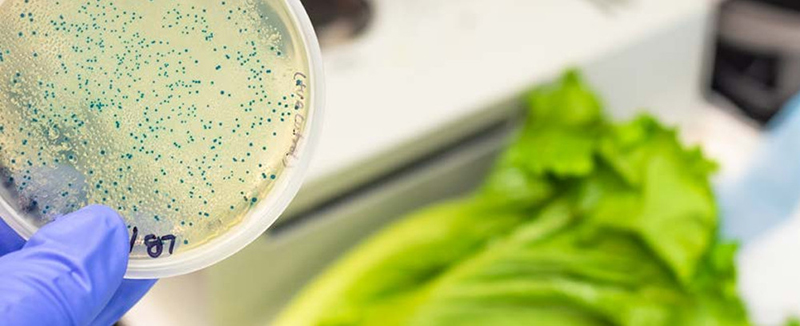

Bonduelle s’engage et dévoile sa 1ère offre “Sans Résidu de Pesticides”…

…de salades prêtes à l’emploi et de maïs en conserve

Une nouvelle offre qui illustre l’ambition du Groupe, pour construire un futur meilleur par l’alimentation végétale.
La marque référente du bien-vivre par l’alimentation végétale propose en 2019 une nouvelle gamme de salades prêtes à l’emploi et une référence de maïs en conserve garanties sans résidu de pesticides (1) , idéales pour les amateurs de « bien-manger » et en quête de produits sains.
Une alternative plus saine pour redécouvrir tout l’attrait culinaire des salades
Les salades prêtes à l’emploi, l’un des 5 légumes les plus consommés par les Français (2)
La gamme “sans résidu de pesticides” composée de trois références de salades prêtes à l’emploi sans résidu de pesticides, sans OGM (3) et sans conservateur, comme toutes les salades en sachets, est disponible en GMS depuis janvier 2019.

MÂCHE SANS RÉSIDU DE PESTICIDES
avec ses tendres feuilles vertes et sa subtile saveur de noisette, elle est assurément l’une des salades favorites des gourmands.
Accompagnée de crudités et de noix, elle est d’autant meilleure !

JEUNES POUSSES D’ÉPINARDS SANS RÉSIDU DE PESTICIDES
légèrement sucrées, elles sont parfaites à déguster crues en salade.

ICEBERG SANS RÉSIDU DE PESTICIDES
la célèbre laitue est le choix idéal pour réaliser des salades hyper croquantes ou pour ajouter une touche végétale aux burgers et sandwichs variés.
MÂCHE SANS RÉSIDU DE PESTICIDES
Poids : 100 g – PVC : 1,59 €
JEUNES POUSSES D’ÉPINARDS SANS RÉSIDU DE PESTICIDES
Poids : 90 g – PVC : 1,99 €
ICEBERG SANS RÉSIDU DE PESTICIDES
Poids : 250 g – PVC : 1,99 €
Sans résidu de pesticides, sans conservateur et sans OGM… Le maïs en conserve Bonduelle a tout pour plaire !
Consommé par plus d’un foyer français sur 2 (4) , le maïs est l’un des ingrédients favoris des Français. Bonduelle leur propose dès mars 2019 une nouvelle référence en conserve qui ne comporte aucun résidu de pesticides (5) . En complément, les consommateurs bénéficient toujours de l’assurance d’un maïs sans OGM, sans conservateur (6) et sans sucres ajoutés.
Avec cette nouveauté, la marque permet aux gourmands soucieux de leur alimentation de retrouver tout le croquant et le bon goût du maïs. Véritable innovation dans le rayon, ce nouveau produit est idéal pour agrémenter d’une touche délicieusement croquante les salades et les plats plus élaborés.

LE MAÏS SANS RÉSIDU DE PESTICIDES
Disponible au rayon légumes en conserve en 2 formats
Poids : 300 g – PVC : 0,99 €
Poids : 3x 150 g – PVC : 1,99 €
Bonduelle, une marque toujours à l’écoute des attentes des Français
Avec le lancement de la gamme de salades prêtes à l’emploi et du maïs en conserve « Sans résidu de pesticides », Bonduelle souhaite répondre aux préoccupations des consommateurs de plus en plus tournés vers un mode de consommation plus sain, responsable et respectueux de l’environnement. Se montrant plus soucieux de leur alimentation, 30% des Français veulent recourir à une alimentation plus responsable (7).
Le développement de nouveaux modes de production
Depuis plus de 160 ans, Bonduelle travaille avec ses partenaires agricoles au développement d’une agriculture toujours plus responsable, en les accompagnant au quotidien vers la transition agroécologique. La marque les encourage ainsi à adopter des pratiques culturales plus respectueuses de l’Homme et de la planète. Bonduelle collabore avec des producteurs implantés en Pays de Loire, en nord Vendée et en Bretagne pour les salades sans résidu de pesticides et avec des producteurs du Sud-Ouest pour le maïs sans résidu de pesticides.

Animée depuis toujours par l’exigence de proposer des légumes de qualité, d’assurer le respect de l’environnement et de la biodiversité, la marque a mis en place dès 1996 une charte agronomique.
Signée par 96% de ses agriculteurs partenaires, elle témoigne de l’engagement continu de Bonduelle en faveur des techniques agricoles respectueuses de l’environnement.
Un dispositif qui démontre la volonté de bien faire de l’entreprise et qui lui permet de continuer de proposer aux consommateurs le meilleur des légumes.
C’est dans cette démarche constante d’amélioration qu’une gamme inédite garantie « Sans résidu de pesticides » est aujourd’hui proposée aux consommateurs.
L’ambition de Bonduelle de réduire la teneur en résidu de pesticides sur l’ensemble de ses légumes fait partie intégrante de cette charte agronomique. Avec ses nouveautés garanties sans résidu de pesticides, la marque va plus loin dans sa démarche d’agriculture responsable. Bonduelle met en place des techniques culturales alternatives (par exemple, le désherbage mécanique, le strip-till (8) , le biocontrôle (9) , l’utilisation de filets anti-insectes… etc) et encourage de nouvelles pratiques :
UN SUIVI DE PRESSION DES NUISIBLES
Bonduelle s’appuie sur différents réseaux de piégeage qui permettent de suivre les populations d’insectes ravageurs en temps réel, de façon fiable et sans relevés fastidieux.

UN CONTRÔLE DE 100% DES PARCELLES
nos salades et maïs sont contrôlés par des laboratoires indépendants accrédités qui s’assurent du respect de la limite de quantification.
Souhaitant faire évoluer les méthodes culturales et inciter les acteurs de l’industrie agricole vers la transition agroécologique, Bonduelle s’engage en faveur de l’environnement. Porté par son nouveau manifesto « La nature, notre futur », l’engagement de Bonduelle démontre une nouvelle fois son ambition d’être le référent du bien-vivre par l’alimentation végétale.
Les résidus de pesticides ? Késako ?
Un résidu de pesticides est le reliquat de l’emploi d’une substance naturelle ou chimique utilisée pour protéger les cultures.
La mention “Sans résidu de pesticides” permet de garantir qu’aucune molécule de pesticides chimique recherchée n’a été retrouvée à une concentration supérieure à la limite de quantification. Pour s’en assurer, Bonduelle travaille avec des laboratoires externes accrédités, chargés de veiller à l’absence de résidus quantifiables. Ainsi, ce sont plus de 500 molécules pour le maïs et 300 molécules pour les salades qui sont scrutées lors des tests réalisés.
Avec les salades prêtes à l’emploi et le maïs en conserve “Sans résidu de pesticides”, les consommateurs sont assurés que les légumes ne contiennent pas de pesticides ou en quantités si infimes qu’elles sont impossibles à quantifier.
(1) Dans la limite de quantification (<0,01ppm) pour une liste prédéfinie de molécules analysées
(2) Source Kantar Worldpanel 2016 – (3) Organisme Génétiquement Modifié – (4) Taux de pénétration Maïs 56,3% KANTAR CAM P13 2018 Total distribution
(5) Dans la limite de quantification (<0,01ppm) pour une liste prédéfinie de molécules analysées
(6) Conformément à la réglementation en vigueur – (7) Sondage Ifop pour WWF France, « Les Français, la consommation écoresponsable et la transition écologique », Octobre 2017
(8) Le labour en bande. Cette technique consiste à ne labourer qu’à l’endroit où l’on va semer.
(9) Produits biologiques de protection des plantes tels que des insectes, des microorganismes, des phéromones, des huiles essentielles pour protéger les cultures.
À propos de Bonduelle
Entreprise familiale créée en 1853, Bonduelle s’est donné pour mission « d’être le référent mondial qui assure le bien-vivre par l’alimentation végétale ». Privilégiant innovation et vision à long terme, le Groupe diversifie ses métiers et ses implantations géographiques. Ses légumes, cultivés sur 128 000 hectares, sont commercialisés dans 100 pays, sous différentes marques, dans différents circuits de distribution et dans toutes les technologies. Doté d’un savoir-faire agro-industriel unique avec 57 sites industriels ou d’auto-production agricole, Bonduelle produit sur les meilleures zones de culture au plus près de ses clients.
Être le référent mondial qui assure le bien-vivre par l'alimentation végétale.

Bonduelle, votre source d'inspiration et d'envie de légumes !
www.bonduelle.fr
© Copyright & Crédits Photos : © Bonduelle | Tous droits de reproduction réservés





